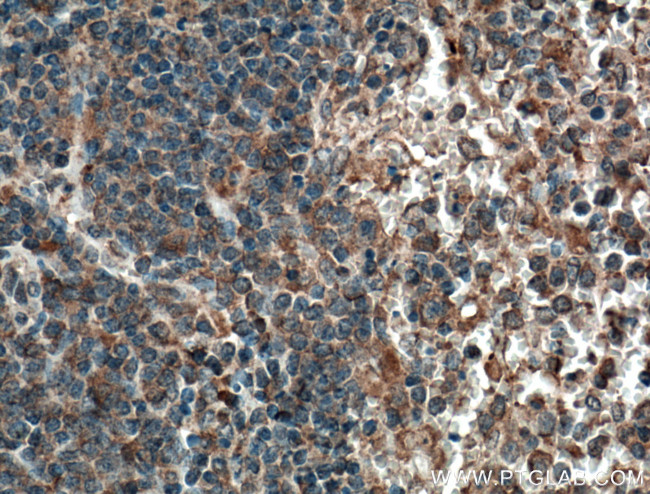
CCRL2 Antibody in Immunohistochemistry (Paraffin) (IHC (P))

Search
Proteintech
CCRL2 Monoclonal Antibody (2C1E11)
{{$productOrderCtrl.translations['antibody.pdp.commerceCard.promotion.promotions']}}
{{$productOrderCtrl.translations['antibody.pdp.commerceCard.promotion.viewpromo']}}
{{$productOrderCtrl.translations['antibody.pdp.commerceCard.promotion.promocode']}}: {{promo.promoCode}} {{promo.promoTitle}} {{promo.promoDescription}}. {{$productOrderCtrl.translations['antibody.pdp.commerceCard.promotion.learnmore']}}
产品信息
66611-1-IG
种属反应
宿主/亚型
分类
类型
克隆号
抗原
偶联物
形式
浓度
规格
纯化类型
保存液
内含物
保存条件
运输条件
产品详细信息
Immunogen sequence: MWAPYNIAF FLSTFKEHFS LSDCKSSYNL DKSVHITKLI ATTHCCINPL LYAFLDGTFS KYLCRCFHLR SNTPLQPRGQ SAQGTSREEP DHSTEV (250-344 aa encoded by BC025717)
靶标信息
CCRL2 (C-C chemokine receptor-like 2), also known as chemokine receptor X, human chemokine receptor (HCR), CRAM-A or CRAM-B, is a seven pass transmembrane protein expressed by monocytes, neutrophils, and dendritic cells of immunal tissues (predominanly spleen, fetal liver, bone marrow and lymph node). It shares over 40% homology with other C-C chemokine receptors but does not share the conserved DRY motif which is among the important motifs necessary for signalling and ligand-binding. C-C chemokine receptors are G-protein coupled, seven pass transmembrane domain proteins whose major physiological role is to function in the chemotaxis of T cells and phagocytic cells to areas of inflammation.
仅用于科研。不用于诊断过程。未经明确授权不得转售。
生物信息学
蛋白别名: atypical chemokine receptor 5; C-C chemokine receptor-like 2; chemokine (C-C motif) receptor-like 2; Chemokine receptor CCR11; Chemokine receptor X; MGC116710; Putative MCP-1 chemokine receptor; unnamed protein product
基因别名: ACKR5; CCR11; CCR6; CCRL2; CKRX; CRAM; CRAM-A; CRAM-B; HCR
UniProt ID: (Human) O00421
Entrez Gene ID: (Human) 9034